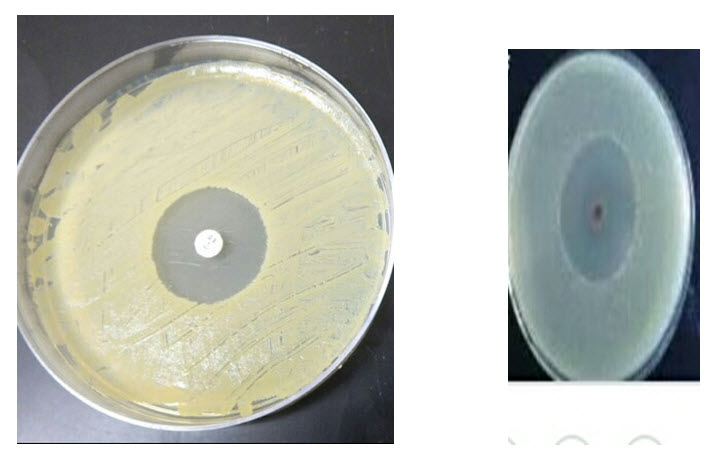

{ DOWNLOAD AS PDF }
ABOUT AUTHORS
Patil N.B.*, Patil K.B., Wagh M.N., Patil A.A,
Department of Pharmacy, Ahinsa Institute of Pharmacy,
Dondaicha, Maharashtra, India
ABSTRACT
The methanol extract of murraya koenigii (leaf) were investigated for their antibacterial activity against staphylococcus aureus using cup plate agar diffusion method and methanol extract produces best results. various investigation like physiochemical standard ,preliminary phytochemical screening of the plant was carried out and parameter were reported. The present paper deals with investigation of various phytochemical present in methanol extract and in vitro antibacterial activity against the s.aureus .the literature survey does not exist anti bacerial activity of murraya koenigii (leaf) in methanol extract against s.aureus.it is concluded that the plant studied may source of antibacterial plant.
[adsense:336x280:8701650588]
Reference Id: PHARMATUTOR-ART-2643
|
PharmaTutor (Print-ISSN: 2394 - 6679; e-ISSN: 2347 - 7881) Volume 7, Issue 02 Received On: 24/11/2018; Accepted On: 11/01/2019; Published On: 01/02/2019 How to cite this article: Patil, N.B., Patil, K.B., Wagh, M.N. and Patil, A.A. 2019. Pharmacognostical, Preliminary phytochemical screening and Antibacterial activity of methanol Extract of Murraya koenigii. PharmaTutor. 7, 2 (Feb. 2019), 18-20. DOI:https://doi.org/10.29161/PT.v7.i2.2019.18 |
INTRODUCTION
The Murrayakoenigii (Curry tree) is a tropical to sub tropical tree in the family Rutaceae, which is a native in India. (en.m.wikipedia.org) Murraya koenigii is semi deciduous, aromatic smell spreading shrub or tree with strong woody stem but slender with the stem which is dark green to brownish in color the tree is 4-8.7 m tall, with a trunk up to 81 cm diameter, the diameter of main stem is about 16 cm. [Ganesan P.et al., 2013]
Curry leaf plant to have flowers and vibrant green leaves throughout the spring ,summer and in rain fall.[Kureel BS et al., 1970] the leaves of murrayakoenigii are used herbs in Ayurveda ,Siddhi Medicine in which they are ant diabetic activity ,antibacterial activity ,anti-emetic ,anthelmintic ,antidiarrheal ,antipyretic and wound Healing effect.[Manshu Jain et al.,2017] The leaves and fruits are also a source of an essential oils which finds use as a fixative for heavu type of soap perfumes.[Manisha Vats et al.,2009] these plants are ingested as decoctions , teas and juice preparations to treat respiratory infection.[Abhishek Mathur et al., 2011]
Compounds found in curry tree leaves , stem, Barks, seed certain Cinnamaldehyde ,Carbazole alkaloids including mahanimbine, girinimbine. [en.m.wikipedia.org] and also contain Bismahanine, Murryamine, Murrayafoline-A, Bi-koeniquinone-A, Mukonine -C, Murayazolinol, Mikonine-B, Koenioline, Murrastifoline, xynthyletin, koenigine-Quinone-A and B for therapeutic purpose of folk people. [Anwar F. et al., 1973;Curry leaf and its use 1962; Priyanka Gupta et al., 2012;Ragunathan K. et al.,1985].
Material and methods
Plant material
The leaves of plant murrayakoenigii (Rutaceae) was collected from the local area of shirpur.
Extraction
Freshly collected plant of murrayakoenigii was dried and then powdered using a mixer.4 gm. of plant powder was taken in Iodine flasks and adds 100 ml of methanol was added to Iodine flask. Flask were closely tight kept for 30 Hrs.these were occasionally shaken after it was filtered and marc was pressed. The entire extract of murrayakoenigii leaves was evaporated to dryness in evaporator.Extractive yield was calculated .the yield of extracts is depicted in table no.1
Physical Evaluation
Drug was evaluated for following physical parameters using referred methods and values obtained are depicted in table no.2.
1.Moisture content (loss on drying)
2. Total ash values
3. Water soluble ash value
4. Extractive value
5. Acid insoluble ash value
Phytochemical Screening-
Preliminary phytochemical screening was performed to identify phytochemicals in each extract of murrayakoenigii.the phytochemicals were detected by color tests as depicted in table no.3
Antibacterial activity-
The antibacterial activity of the murrayakoenigii was tested using Gram positive S.aureus .the bacterial strain was maintained on Nutrient agar at 40 C and sub cultured into nutrient broth in our laboratory.
Agar diffusion method -
In vitro antibacterial activity of crude extracts was studied against gram positive S. aureus by the agar plate diffusion method.
Nutrient agar was used as bacteriological medium. The extracts of crude drugs is used test sample and ampicillin is standard sample.100 µl of inoculum was aseptically introduced as the surface of sterile agar plates and sterilized- Shaped glass rods was used for even distribution of the inoculums .wells were prepared in the agar plates using a sterile cork barer.100 µl of test and standards sample extract was introduced in the well.the plates were introduced at 37 oC for 24 Hrs. .The zone of inhibition produced by extract was measured and compared with those produced by Antibiotic ampicillin. antibacterial activity of murrayakoenigii methanol extracts is depicted in table no.4.
Pharmacognosy of murraya koenigii
Murrayakoenigii commonly known as curry leaf is a small tropical to sub-tropical shrub or tree that typically grows to 6-15 tall and is noted for a pungent, aromatic .this tree is native to moist forests in India and Sri-lanka. Interesting house plant; the leaflets of which can snipped for cooking. [www.missouribotanicalgarden.org]
Flowers of curry leaves is small , white fragrant and funnel shaped ,the diameter of flower is 1.2 cm in the fully opened from each cluster bear approximately 60 to 90 flowers at a time after flowering at once. Stem is brown to dark green in color, with dots on the bark like small node on it. Bark was peeled off longitudinally under the exposing the white wood under Neath. Fruit of the murrayakoenigii occurs in cluster from varies in 32 to 80 in number. [Manshu Jain et al.,2017]

Fig.no.1 Murrya Koenigii plant (Curry leaves)
NOW YOU CAN ALSO PUBLISH YOUR ARTICLE ONLINE.
SUBMIT YOUR ARTICLE/PROJECT AT editor-in-chief@pharmatutor.org
Subscribe to Pharmatutor Alerts by Email
FIND OUT MORE ARTICLES AT OUR DATABASE
RESULT AND DISCUSSION -
The yield of extract in methanol was found to be 17.1% on dry weight .ash parameter, Extractive values were evaluated. The preliminary phytochemical screening of Extract showed the presence of Carbohydrate, Glycoside, Alkaloids and Proteins are detected.
Antibacterial screening data showed that methanol extract has exhibit antibacterial activity.
Table 1.Yield of Extract
| Sr.no. | Extract | % Dry weight |
| 1 | Methanol | 17.1 |
Table 2.Physical Evaluation

Table3. Preliminary Phytochemical screening.

Where-
(+) - sign indicate presence and (-)- sign indicated absence of constituent.
Table 4.Antibacterial activity.

CONCLUSION
Methanol extract showed that presence of alkaloids, carbohydrate, Proteins, volatile oils and glycosides.
From antibacterial screening it was found that methanol extract showed Best antibacterial activity in the concentration 100 µg/ml .the methanol extract showed the zone of inhibition 6.2 mm .this is an indicated the methanol extract of murrayakpenigii shows they inhibit growth of microorganism.
REFERENCES
1. Abhishek Mathur,Satish K.Verma,Santosh K.Singh,GBKS Prasad,V.K.Dua (2011), Investigation of the antimicrobial ,Antioxidant and anti inflammatory activity of compound isolated from murraya koenigii,International Journal of Applied Biology and Pharmaceutical Technology,2(1),470-477.
2. Anwar F. ,Masaldan AS,Kapil RS(1973),Synthesis of murryacine,oxidation with DDQ of activated aromatic methyl group of the alkaloids of murrayakoenigiispreng,Indian J.Chem.,11,1314-1315.
3. Curry leaf and its uses (1962), council of science and Indus Research,6,125-127.
4. Ganesan P,Phaiphan A,Murugan Y.(2013),Comparative study of bioactive compounds in curry and coriander leaves:An update ; Journal of chemical and pharmaceutical Research,5(1).590-594.
5. en.m.wikipedia.org
6. Kureel BS, Kapil RS, PopaliSP(1970),Two novel alkaloids from murrayakoenigii: mahnombicine and bicyclomahanimbicine, chemInd(London),29,958.leaf(murrayakoenigii): A spice medicinal property, MOJ Biology and medicine,2(3),236-256.
7. Manisha vats,Harneet singh,Satish Sardana (2009),Phytochemical screening and antimicrobial activity of roots of murraya koenigii spreng.(Rutaceae),Brazilian Journal of Microbiology ,42,1569-1573.
8. Manshu Jain, Rita Gilhotra,Ravindra pal singh ,JitendraMitthal(2017),Curry
9. Priyanka Gupta,AlokNahata,VinodK(2012), An update on murrayakoenigii: A multifunctional Ayuredic herb, Journal of Chinese integrative medicine,9(8),824-833.
10. Ragunathan K.,Mitra R.(1985),Pharmacognosy of Indigenous drugs,Central Council for Research in Ayurveda and siddha ,11,433.
11. missouribotanicalgarden.org
NOW YOU CAN ALSO PUBLISH YOUR ARTICLE ONLINE.
SUBMIT YOUR ARTICLE/PROJECT AT editor-in-chief@pharmatutor.org
Subscribe to Pharmatutor Alerts by Email
FIND OUT MORE ARTICLES AT OUR DATABASE

